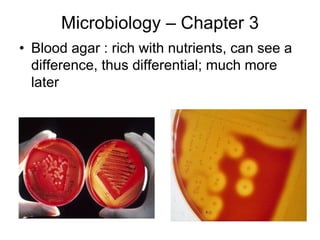
Microbiology – Chapter 3
• Blood agar : rich with nutrients, can see a
difference, thus differential; much more
later

The document summarizes microbiology techniques for culturing and observing microbes. It describes the five steps for culturing as inoculation, isolation, incubation, inspection, and identification. Inoculation introduces microbes to growth media. Isolation produces pure cultures on agar plates. Incubation allows growth under optimal conditions. Inspection involves observing colony morphology and staining for microscopy. Identification correlates observed characteristics to identify the microbe. It also explains light and electron microscopy, describing their components, resolutions, and sample preparation techniques like staining.